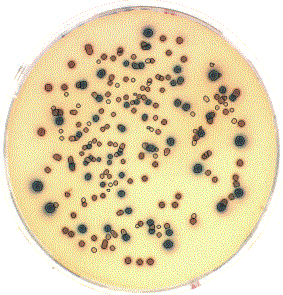

Human overpopulation and its consequences
|

random trip report |
I wrote this in ~2010. Some of the ideas here appear in my more recent essays on human survival (2021), scientific government (2020), and the nature of Nature (2025).
In high school biology class we grew a bacteria colony on a Petri dish. I smeared the agar and put the dish in an incubator. After a couple of days there were some colored dots - bacteria multiplying and consuming the nutrients. I forgot about it for a week, and when I looked again, the dish was covered with gray scum - the bacteria had consumed all the agar and died.
There are plenty of individual human geniuses -
Newton, Gauss, Shakespeare, Beethoven, Einstein -
but as a species we're no different than the bacteria on the Petri dish,
controlled by our drives to survive and reproduce.
In fact, we're more foolish than the bacteria:
we have intelligence,
but we use it to try to pack a few more of our kind into our Petri dish,
thinking we can outsmart nature.

The central problem facing life on Earth is human overpopulation. This creates a chain reaction of consequences that disrupt the natural processes that produced life, cause massive extinction of non-human life, and in the worst case may lead to the extinction of human life. Social problems - injustice, economic inequality, genocide, cultural extinction, etc. - exist and should be addressed. But they're insignificant compared to overpopulation. The overpopulation problem will eventually solve itself, as it did in the Petri dish. Is a better outcome possible? Considering human nature, probably not. But we have to try anyway.
Humans versus evolution
Life on Earth ebbs and flows. Species evolve and compete. Every species reproduces faster than is necessary to maintain its population. A limit is reached - food supply, territory, predation, competition. The population declines, and eventually grows again, in a roughly sinusoidal pattern. Mutations occur, some of them providing an advantage. Species diversify and evolve. Evolution has spent billions of years tinkering and inventing. It invented every aspect - biochemical, physiological, cognitive, mental - of every organism, everywhere. It created the web of dependencies between species in an ecosystem. When it comes to bioengineering, evolution is vastly more creative and sophisticated than humans.
Humans have evolved extreme intelligence, giving us absolute dominance over all other species, and eventually - through technology - letting us reshape our entire environment. Intelligence has removed the natural limits on the growth of our population. Except for the occasional plague, famine, and war (whose net effects, thus far, have been relatively minor) human population has grown exponentially over the last 12,000 years. There were roughly 1 million humans in 10,000 BC. As of 2009, the population is 7 billion and growing at about 1.5% per year.
The human population explosion has had various consequences:
- Over the last 20,000 years, humans have deforested a major fraction of the Earth.
- In the last few centuries, humans have burned through a supply of carbon fuel that has been accumulating in the Earth for several billion years. The resulting carbon emissions are causing global climate change, with possibly catastrophic consequences.
- Humans have polluted the Earth, and especially its seas, with toxic chemicals, radioactive waste, and plastic debris. Many of these synthetic poisons will not disappear naturally for hundreds of thousands of years.
- Producing enough food for 7 billion humans has required farming techniques that pollute, reduce biodiversity, and destroy topsoil.
- Humans have colonized most of the animal-friendly land on Earth, and made it unliveable for most other species.
- Humans have hunted to extinction numerous species, either because they threatened us or fed us.
- These factors in combination are causing extinction of non-human species (even those we don't eat or fear) on an unprecedented scale - about 1,000 times faster than the historical average.
What do we do now?
Humans hijacked Earth and are taking it on a joy-ride to oblivion. How can we stop this madness and get things back on the right track? Should we assume that human intelligence will come to the rescue once again, that Science will deliver silver bullets that re-bury carbon, degrade plastic, and grow food in the desert - that let us sustain our 7 billion, and maybe pack in a few more billion?No. This kind of thinking is what got us into trouble. Instead, we need to swallow our pride and return control to nature.
We must re-enable evolution - greatly reducing or eliminating human interference with evolution. The first step to doing this is to reduce human population.
Re-enabling evolution is a radical idea. It goes beyond sustainable energy and recycling. It means letting the Earth revert to its state roughly 20,000 years ago - letting huge areas of land revert from cropland to wilderness, letting predators return to their natural range, demolishing highways, dams, and levees.
Does this mean that humans must revert to hunting and gathering? No. I think we can re-enable evolution while keeping most of our technology: global communication, labor-saving devices, efficient agriculture, local and long-distance transportation (although not in their current forms). We can live in ways which, although much different than how we live now, are at least as comfortable and rewarding.
What is the ideal human population?
If our population continues to grow, nothing else we do matters: we're headed for disaster. We need to decide - as a species - what we want our population to be, how to attain it, and how to maintain it.
So, what is the ideal human population of Earth? Some people equate this question with: "how many humans can sustainably live on Earth?". That is NOT the question. More is not necessarily better.
The pre-agricultural human population was on the order of 1 million. If we returned to that level, it would be easy to minimize our impact on Earth, while still ensuring our survival as a species.
But there are valuable aspects of human life - culture, art, society - that rely on having a critical mass of people, perhaps living close to one another. Cities are desirable in this sense. But how many, and how big? Production of food and goods requires a certain population for economy of scale. Maintaining science and technology also requires people.
If we can figure out how to live efficiently, I think about 50 million people could live on Earth without impacting evolution significantly. That population would allow for a few cultural centers of a million or so people, while at the same time letting people live outside of cities with little or no pressure for land, and allowing most of the Earth to revert to its natural state.
The combination of low population and technology unlocks wonderful possibilities for human society. People can live where and how they want. There will be no more desperate struggle for survival and security. With the elimination of rat-cage-like overcrowding, people will actually seek contact with one another. Utopian visions will be realizable.
Technology
Technology works wonderfully for some things. It lets us build machines to handle our basic needs (food and housing) in a tiny fraction of our time. Medical technology extends our lives and reduces suffering. I myself develop technology for a living.
Some people believe that by using certain types of technology on a large scale - genetic engineering, technology-based agriculture, carbon sequestration, etc. - we can solve environmental problems. Some even believe that greater population means more geniuses, which means more technological progress, and therefore we should grow our population even further.
I call such uses of technology "playing God". The belief that humans can save the Earth by playing God can't be proved or disproved. However, my gut instinct (and this is the essence of this essay) is that the belief is totally and dangerously wrong. Some factors:
- Essentially every large-scale application of technology has had unexpected negative consequences. In some cases we can patch these problems with more technology. But inevitably we'll reach a point where the problems and unfixable and irreversible.
- Relying on technology is a high-wire act without a net. If technology suddenly becomes unavailable, you fall.
- Although evolution is the aggregation of dumb processes, it is, in a sense, smarter than humans will ever be. We humans will never fully understand, much less reproduce, what evolution has created. Technology is primitive and impotent compared with evolution.
Religion's Big Lies
Many aspects of organized religion are harmful to life on Earth.
- A central feature of almost all creation myths is that humans were created separately from the rest of nature, and that the rest of nature was created to serve us. This is a horrible and dangerous falsehood.
- Belief in a supreme being eliminates a sense of personal responsibility for the fate of Earth. God wouldn't allow Earth to become a lifeless desert - would He?
- Religions promote "faith": a brainwashed, unquestion acceptance of existing power structures, fictional ideologies, and the social status quo. Faith-zombies are unlikely to wake up to the reality and consequences of human overpopulation.
- The false claim that "(human) life is sacred" is a catch-all argument against any form of population control.
- Religions compete in an evolutionary arena. Their success is not based on truth or merit, but rather on their ability to gather adherents. It's relatively easy for parents to indoctrinate their children. So it's not surprising that many religions discourage birth control and encourage over-reproduction by their adherents.
Capitalism and economic growth
Various studies have shown that rich people have fewer kids, leading to the idea (articulated by the UN World Population Conference in 1974) that "development is the best form of contraception".
There's a gap in this logic: in global capitalism as currently practiced, development doesn't enrich everyone uniformly. Quite the opposite: wealth disparity continues to grow. So economic growth per se doesn't achieve population control.
Furthermore, population growth is good for the global economy. It creates new markets and provides cheap labor. So in the business media, "growth" is assumed to be desirable. It's not, of course.
In the short term, population control may be bad for business. We need to accept this. In the longer term - once we learn how to act like Buddhas instead of bacteria - humans have will everything they really want. But that's a topic for a different soapbox.
Nationalism
Nationalism is a mortal enemy of responsible species-level behavior, and population control in particular. Nationalism means that countries act selfishly, and assume that other countries are trying to screw them.Poor countries distrust supranational population control efforts because they fear (justifiably, based on history) that this means having the will of rich countries imposed on them. However, our problems, and their likely solutions, are species-level, and require supranational action.
We can't eliminate nationalism, but we need to figure out how to work around it.
Media and politics
A common headline:World population to increase by 70 million
The story then goes on to speculate on how we're going to provide food and energy for all these new people. The question of whether the population really must increase by 70 million is never raised.
Nor is population control ever discussed in the political arena. If a politician were to raise the population issue, his opponents would find it easy to hysterically characterize this is anti-religion, racist, government run amok, and so on. It would be political suicide in the current environment.
Changing this situation is the necessary first step to saving the world. Citizens of countries with free speech can do something about this - bring the population problem into the political arena, detach it from hysterical associations, and demand that politicians take a stand on it.
How can we reduce human population?
Reducing human population doesn't require forced sterilization, eugenics, mass extermination, or draconian laws; it just requires a sustained decrease in the global birth rate.If couples have 1 child on average, the population will decrease by 50% each generation. World population would go from 7 billion to 100 million in about 6 generations - just 120 years.
Here's a road map for how this could happen:
- Achieve awareness of the need for population reduction among a global critical mass of people.
- Create an international "Population Control Forum" (PCF) to formulate and promote policies for the population reduction process. This must be a non-governmental organization; national governments have demonstrated a total inability to jointly perform these functions.
- The PCF formulates a plan: how should population decrease over time, and what birth rate is necessary to achieve this.
- The PCF defines a set of "best practice" national policies to
achieve population reduction,
possibly including:
- Free government-provided contraception.
- Education programs (formal and adult) on the need for population control, and on contraception.
- Wealth redistribution (tax and welfare structure) to encourage the target offspring function (e.g. tax structures that discourage parenting > 2 children, and that encourage 0 or 1).
- Wealth redistribution policies that reduce income disparity and reduce poverty.
- Countries meeting PCF targets practice economic sanctions and immigration controls against countries not meeting the targets.
The idea is to gradually make life more comfortable for people and societies that are working to reduce population, and less comfortable for others.
Initially only a few countries will pay attention to PCF's recommendations. As the "gross national happiness" of these countries increases, less enlightened countries will hopefully come on board.
What can you do?
- Think about the ideas I've presented here, and talk about them with your friends and relatives.
- Don't despair. Although population control has some very powerful enemies (religion, capitalism, nationalism) it's our only hope.
- Investigate organizations such as Population Connection.
- Write about population control to your elected representatives.
- Try to put population control in the media: write letters to the editor, call in to talk shows, and so on.
- Write about it in Web forums.
- Link to this page.